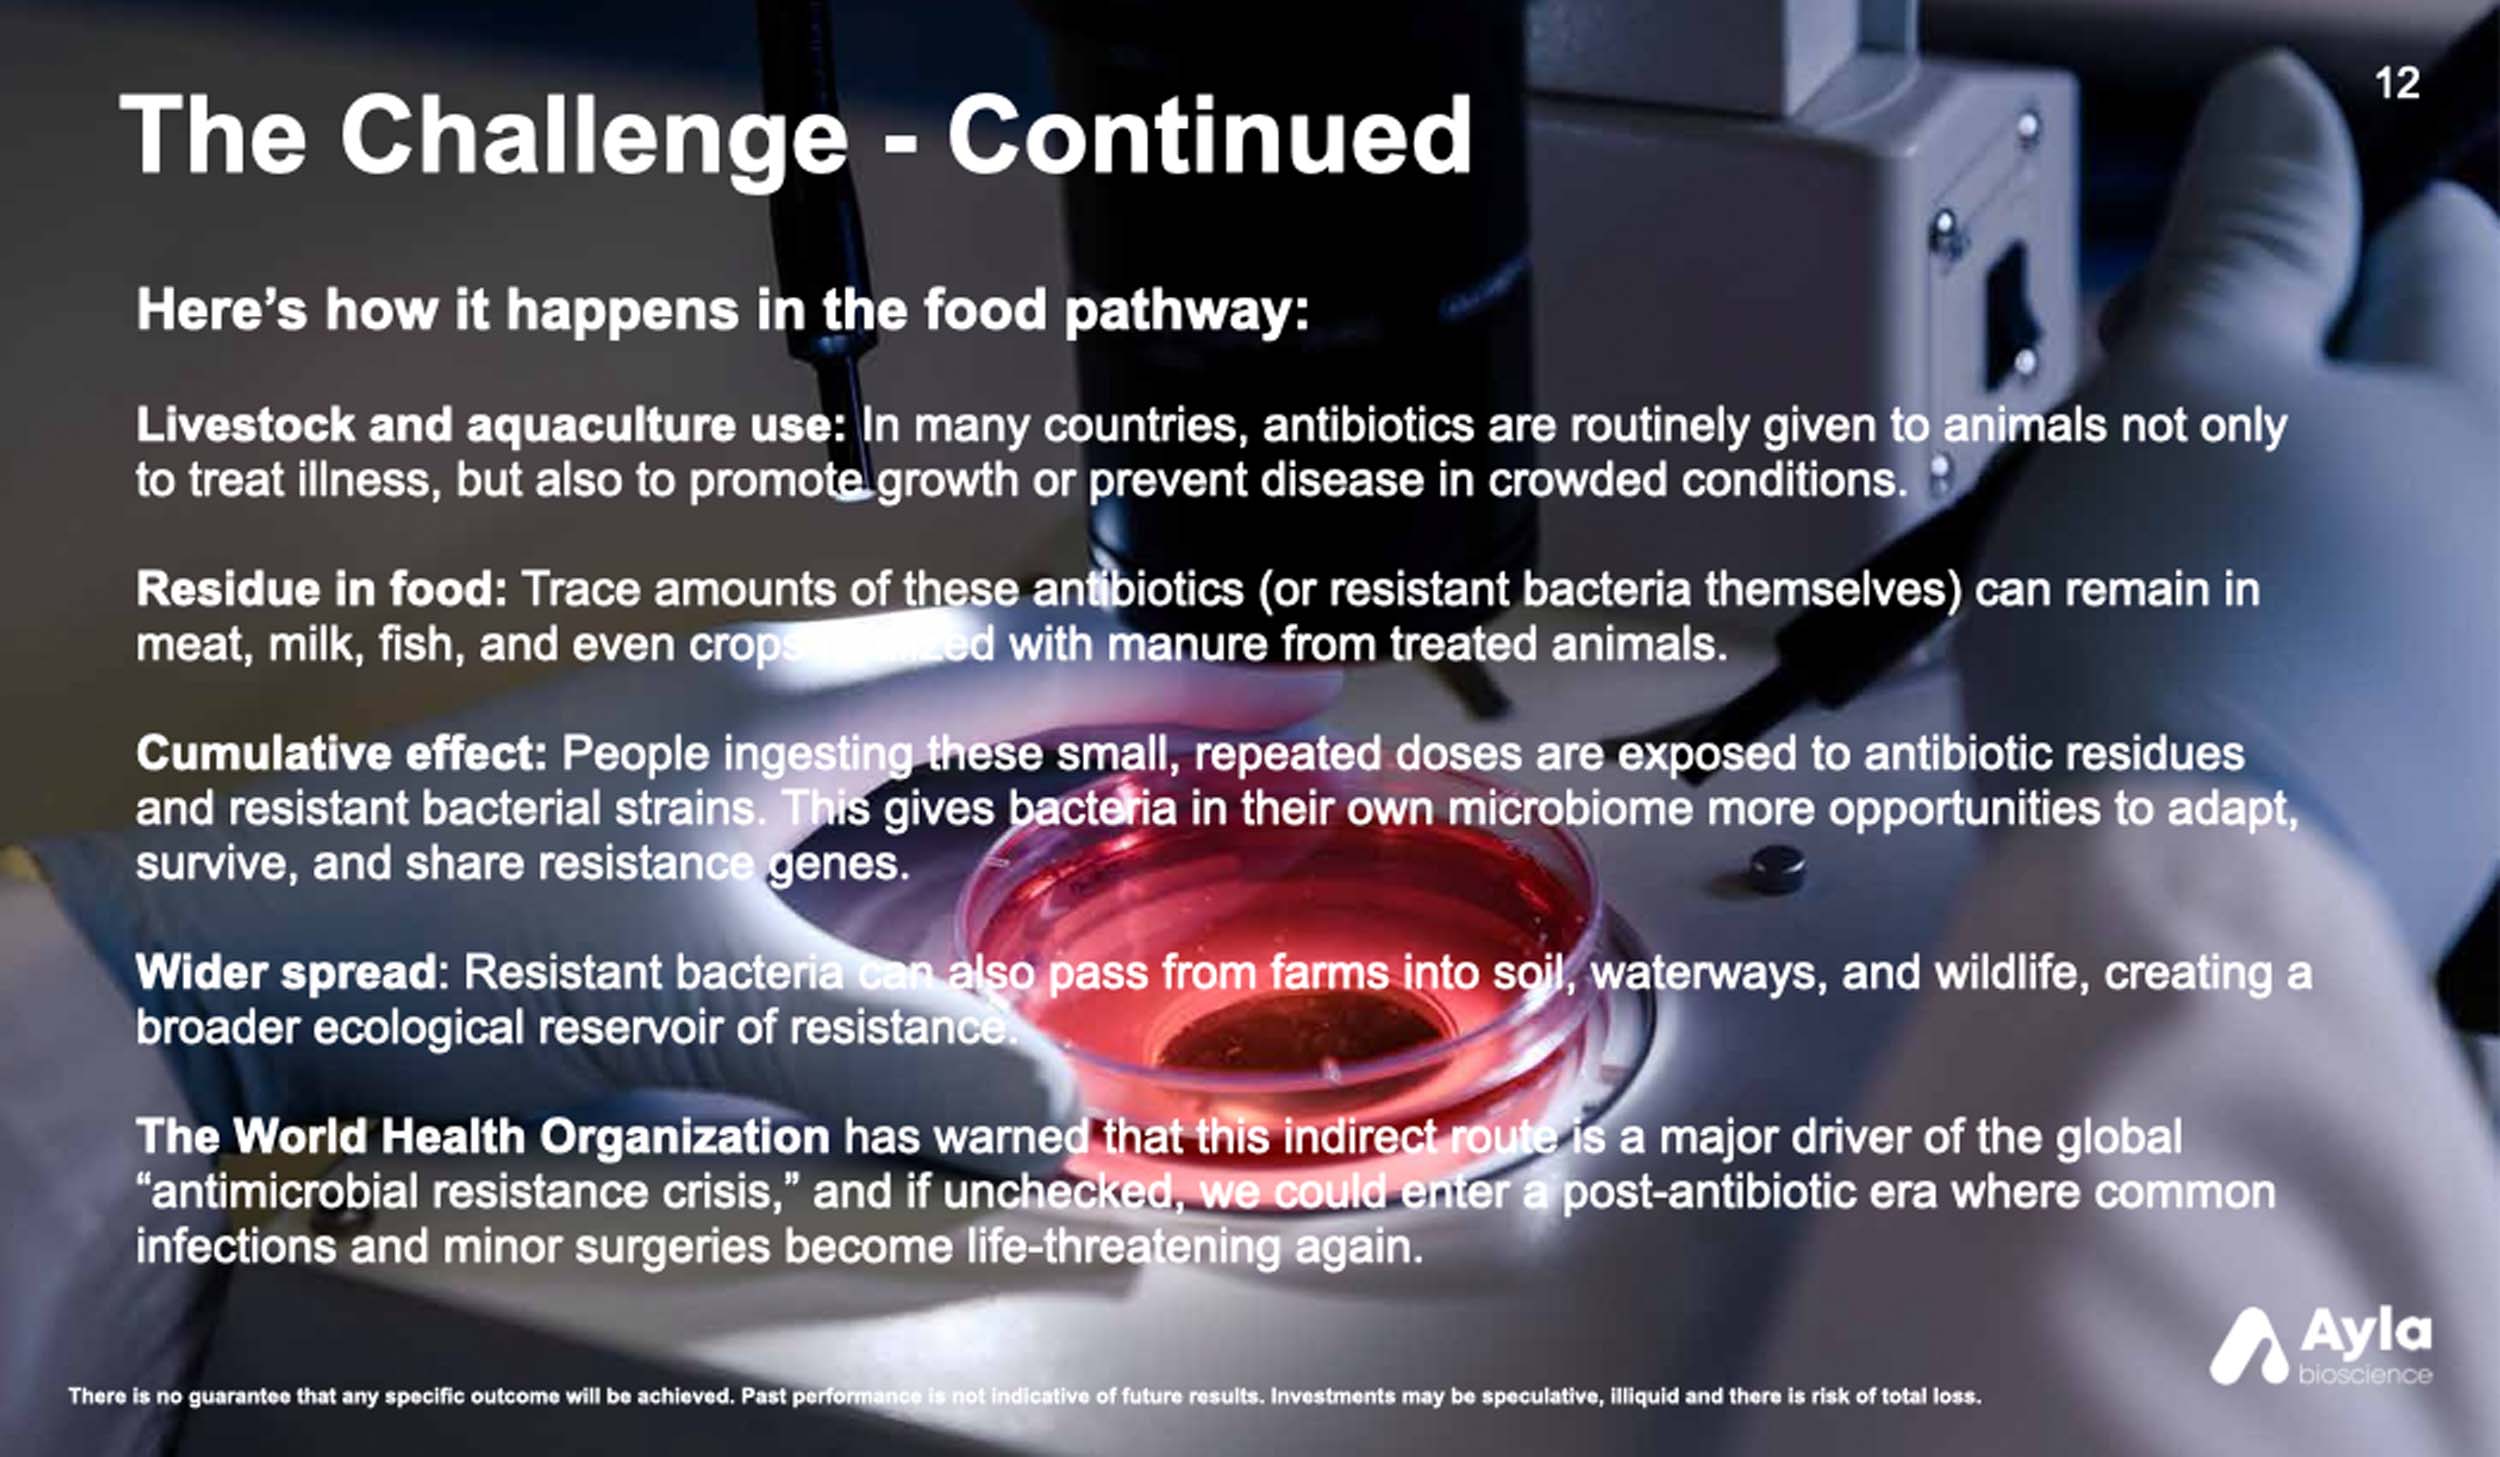

THE FUTURE OF BIO MANUFACTURING IS TODAY
ZeoTech™
A Wholly Owned Division
There is no guarantee that any specific outcome will be achieved. Past performance is not indicative of future results. Investments may be speculative, illiquid and there is risk of total loss.
VISION
Ayla Bioscience’s vision is to revolutionize the functional food industry through the sustainable production and preservation of high-quality, mushroom-based fruits, vegetables, nutraceuticals, vegetable nutraceuticals and other organic products.
MISSION STATEMENT
Our mission is to unleash the potential of plants to produce functional foods, medicines, dietary supplements, cosmetics, and bioactives—improving the health of people and the planet. We develop innovative solutions that enhance human and animal well-being while promoting environmental sustainability, achieving the smallest possible ecological footprint in agriculture.
CLICK THE POWER POINT DECKS BELOW TO LEARN MORE


SUMMARY
Ayla Bioscience is unlocking the full potential of mushrooms and fungi—an untapped engine in the multi-trillion dollar global bio-economy. Leveraging Zeotech’s patented drying technologies and our advanced cultivation capabilities, we’ve built a scalable, high-margin platform already generating sales in the U.S., Europe, Canada, and Colombia.
Our dual-market strategy—anchored by Colombia’s cost-efficient, export-driven operations and Jamaica’s open regulatory framework for psychotropic R&D—gives us first-mover advantage in three rapidly growing categories: gourmet mushrooms, medicinal & psychotropic therapeutics, and high-value consumer products. These verticals, combined with a strong revenue base and diversified global footprint, create the perfect setup for a well-received, near-term NASDAQ IPO.
The acquisition of Zeotech expands our reach far beyond mushrooms—positioning Ayla at the cutting edge of agricultural and sustainable materials innovation. From fruits, vegetables, vegan meats, and plant- based leathers, to medicinal animal feeds and biodegradable mycelium packaging, Ayla’s technology pipeline touches food security, health, and climate resilience—three of the century’s most urgent investment themes.
The result: a rare combination of market-ready revenue, breakthrough IP, and cross-sector scalability—the exact formula Wall Street looks for in its next big growth story.